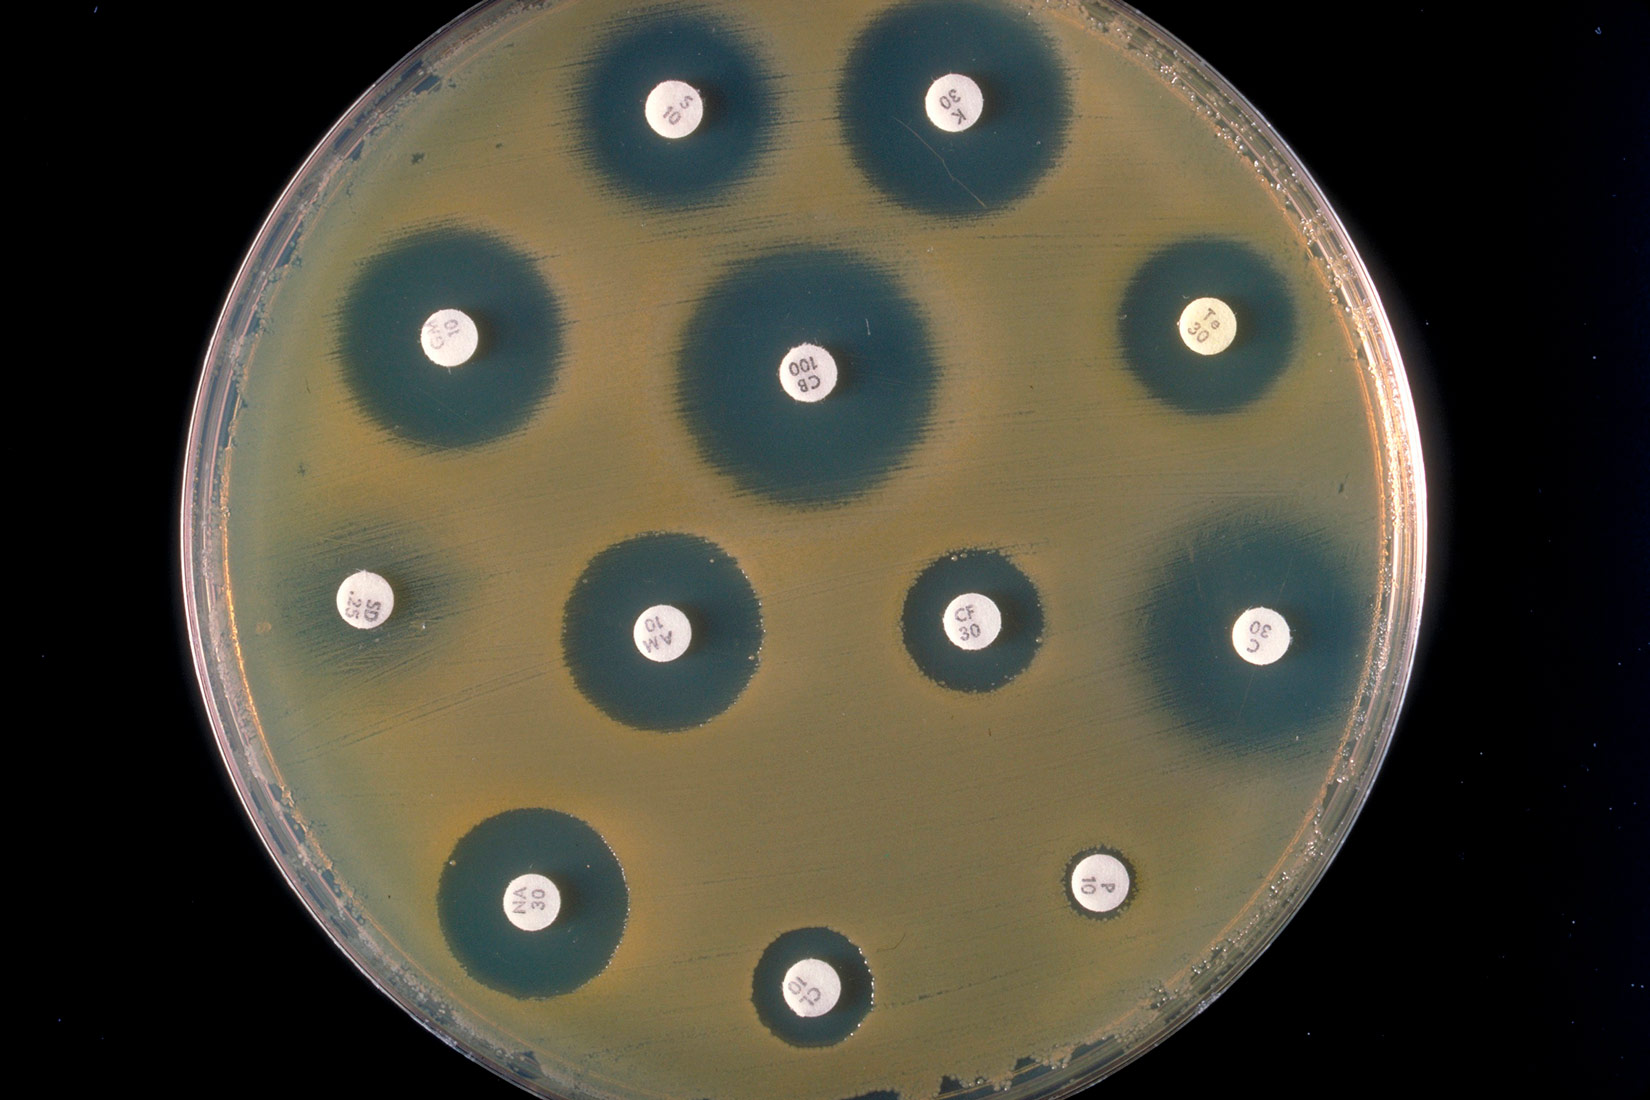
Slika prikazuje antibiogram u obliku kruga smeđe boja. U njegovoj unutrašnjnosti su veliki crni i mali bijeli krugovi.

Najjednostavniji oblici života i stanica
2.1.Najjednostavniji oblici života na Zemlji
Odgovorite na priložena pitanja pri svakom od navedenih primjera i tako si prikupite dio argumenata za raspravu:
- Tko je kliconoša?
- Na koji se način uzročnik prenosi?
- Što su „ulazna vrata“ za ovu infekciju?
- Pojasnite hoće li u navedenom primjeru doći do razvoja i/ili širenja bolesti.
Ljeto je razdoblje kada bi svi trebali malo više paziti na čuvanje namirnica jer visoke temperature često pomažu u razvoju bakterija u mesu, mlijeku, jajima i njihovim prerađevinama. Ivan je posjetio slastičarnicu s bakom i popili su limunadu. Za par dana, na mrežnim stranicama je pročitao da je ta slastičarnica zatvorena zbog salmonele. Trebaju li se on i baka isto testirati s obzirom na to da su bili tamo?
Započnimo s nekim od pitanja na koja biste trebali odgovoriti pri prezentiranju svoje skupine bakterija:
1. Gdje žive (geografski položaj, životni uvjeti i sl.)?
2. Kako možemo utvrditi njihovu prisutnost?
3. Na koji način se hrane?
4. Koja je njihova poveznica sa životom čovjeka? i sl.
Najpoznatije autotrofne bakterije su cijanobakterije. Jedne su od prvih organizama i svojim su postojanjem omogućile razvoj ostalim skupinama organizama. Cijanobakterije hranu proizvode fotosintezom, dok sumpornim bakterijama za proizvodnju hrane nije potrebna svjetlost jer one svoju hranu proizvode kemosintezom, što im omogućava naseljavanje gotovo nepristupačnih područja. Kemosinteza je proces stvaranja hrane korištenjem energije nastale iz kemijskih reakcija (umjesto one dobivene iz organskih tvari ili od sunca). Jedan od najčešćih primjera kemosintetskih organizama su bakterije koje žive na hidrotermalnim ili metanskim izvorima na dnu oceana koje koriste energiju sumpora ili metana za proizvodnju hrane.
Dodatne informacije o navedenim skupinama potražite na poveznicama o gejziru Old Faithful u NP Yellowstone, bakterijama na Arktiku, cijanobakterijama i kratkom evolucijskom pregledu.
Među heterotrofnim bakterijama najbrojnije su saprofitske bakterije. Njihovu ulogu u kruženju tvari i stvaranju humusa već ste izvrsno upoznali na nastavi Prirode. Morske bakterije koriste se za razgradnju prolivene nafte, a u novije vrijeme pokušavaju se naći/uzgojiti rodovi bakterija koje će razgrađivati plastiku. Možemo gotovo bez problema reći da su saprofitske bakterije prvi organizmi na Zemlji koji su se bavili recikliranjem. Svaka od njih prilagođena je razgradnji određenih sastojaka uginulog organizma (različitih ugljikohidrata, bjelančevina, masti i dr.).
U našem životu, važnu ulogu imaju i heterotrofne bakterije vrenja. O njima ćete učiti još i na nastavi Kemije. Razlikujemo bakterije mliječno-kiselog vrenja i bakterije octenog vrenja. Kao što se može naslutiti i iz njihovih naziva, obje skupine imaju važnu ulogu u prehrambenoj industriji. Bakterije mliječno-kiselog vrenja vrlo lako možete „slučajno upoznati“ ako otvoreno mlijeko ostavite na sobnoj temperaturi. One su zaslužne i za proizvodnju jogurta, acidofila i sireva. Bakterije octenog vrenja daju nam ocat, koji je važan spoj u očuvanju tkiva, npr. koristi se u konzerviranju, tj. kiseljenju povrća.
Simbiontske bakterije svojim djelovanjem pomažu drugim organizmima u preživljavanju. Najpoznatije simbiontske bakterije su dušične i crijevne bakterije. Dušične bakterije su organizmi koji uz pomoć biljki mahunarki omogućavaju zelenu gnojidbu tla. Crijevne bakterije čovjeka svojim djelovanjem pomažu u razvoju i održanju imunosti našega organizma. Istražite kako sačuvati crijevnu floru našega probavila, posebice u slučaju (pretjerane) uporabe antibiotika.
Započnimo s nekim od pitanja na koja biste trebali odgovoriti pri prezentiranju svoje skupine bakterija:
1. Gdje žive (geografski položaj, životni uvjeti i sl.)?
2. Kako možemo utvrditi njihovu prisutnost?
3. Na koji način se hrane?
4. Koja je njihova poveznica sa životom čovjeka? i sl.
Najpoznatije autotrofne bakterije su cijanobakterije. Jedne su od prvih organizama i svojim su postojanjem omogućile razvoj ostalim skupinama organizama. Cijanobakterije hranu proizvode fotosintezom, dok sumpornim bakterijama za proizvodnju hrane nije potrebna svjetlost jer one svoju hranu proizvode kemosintezom, što im omogućava naseljavanje gotovo nepristupačnih područja. Kemosinteza je proces stvaranja hrane korištenjem energije nastale iz kemijskih reakcija (umjesto one dobivene iz organskih tvari ili od sunca). Jedan od najčešćih primjera kemosintetskih organizama su bakterije koje žive na hidrotermalnim ili metanskim izvorima na dnu oceana koje koriste energiju sumpora ili metana za proizvodnju hrane.
Dodatne informacije o navedenim skupinama potražite na poveznicama o gejziru Old Faithful u NP Yellowstone, bakterijama na Arktiku, cijanobakterijama i kratkom evolucijskom pregledu.
Među heterotrofnim bakterijama najbrojnije su saprofitske bakterije. Njihovu ulogu u kruženju tvari i stvaranju humusa već ste izvrsno upoznali na nastavi Prirode. Morske bakterije koriste se za razgradnju prolivene nafte, a u novije vrijeme pokušavaju se naći/uzgojiti rodovi bakterija koje će razgrađivati plastiku. Možemo gotovo bez problema reći da su saprofitske bakterije prvi organizmi na Zemlji koji su se bavili recikliranjem. Svaka od njih prilagođena je razgradnji određenih sastojaka uginulog organizma (različitih ugljikohidrata, bjelančevina, masti i dr.).
U našem životu, važnu ulogu imaju i heterotrofne bakterije vrenja. O njima ćete učiti još i na nastavi Kemije. Razlikujemo bakterije mliječno-kiselog vrenja i bakterije octenog vrenja. Kao što se može naslutiti i iz njihovih naziva, obje skupine imaju važnu ulogu u prehrambenoj industriji. Bakterije mliječno-kiselog vrenja vrlo lako možete „slučajno upoznati“ ako otvoreno mlijeko ostavite na sobnoj temperaturi. One su zaslužne i za proizvodnju jogurta, acidofila i sireva. Bakterije octenog vrenja daju nam ocat, koji je važan spoj u očuvanju tkiva, npr. koristi se u konzerviranju, tj. kiseljenju povrća.
Simbiontske bakterije svojim djelovanjem pomažu drugim organizmima u preživljavanju. Najpoznatije simbiontske bakterije su dušične i crijevne bakterije. Dušične bakterije su organizmi koji uz pomoć biljki mahunarki omogućavaju zelenu gnojidbu tla. Crijevne bakterije čovjeka svojim djelovanjem pomažu u razvoju i održanju imunosti našega organizma. Istražite kako sačuvati crijevnu floru našega probavila, posebice u slučaju (pretjerane) uporabe antibiotika.
2.2.Stanica
Stanične strukture
2.3.Stanične diobe
Raznolikost stanica